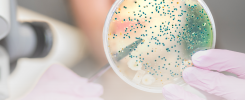

Entre os pacientes que receberam cuidados de saúde mental, aqueles expostos ao lítio em dosagens clínicas padrão tiveram um risco 44% menor de receber um diagnóstico de demência versus aqueles não expostos em um acompanhamento médio de 4,8 anos, relataram Shanquan Chen, PhD, da Universidade de Cambridge, Inglaterra, e colegas no estudo publicado na revista PLoS Medicine.
O uso de lítio foi associado a um risco significativamente reduzido para ambos os subtipos de demência considerados:
- Doença de Alzheimer: HR 0,55 (IC 95% 0,37-0,82)
- Demência1 vascular: HR 0,36 (IC 95% 0,19-0,69)
Os pesquisadores não mediram o risco para outros subtipos de demência, como a demência por Corpos de Lewy ou a demência da doença de Parkinson.
É importante notar que o uso de lítio foi protetor tanto com 1 ano ou menos de uso quanto com uso a longo prazo de 5 ou mais anos. No entanto, exposições de médio prazo – entre 1 e 5 anos de tratamento – não foram significativamente protetoras, embora o grupo de Chen tenha dito que isso provavelmente era apenas um efeito de ser estatisticamente fraco.
“O número de pessoas com demência continua a crescer, o que coloca uma enorme pressão nos sistemas de saúde”, explicou Chen em comunicado. “Estima-se que retardar o início da demência em apenas cinco anos poderia reduzir sua prevalência e impacto econômico em até 40%”.
Não surpreendentemente, 73% dos pacientes no grupo tratado com lítio apresentavam mania ou transtornos afetivos bipolares – uma das indicações mais comuns para o lítio. Por causa disso, os pesquisadores ajustaram para essa comorbidade comum, assim como depressão, idade, sexo, estado civil, etnia, tabagismo, transtornos alcoólicos, uso de antipsicóticos, hipertensão, doença vascular central, diabetes mellitus e hiperlipidemia.
“O transtorno bipolar e a depressão são considerados como fatores de risco aumentado de demência, então tivemos que nos certificar de que isso fosse levado em conta em nossa análise”, observou Chen.
No artigo publicado, os pesquisadores contextualizam como a demência é a principal causa de morte em populações ocidentais idosas. Intervenções preventivas que poderiam retardar o início da demência, ainda que modestamente, teriam um grande impacto na saúde pública.
Não existem tratamentos modificadores da doença atualmente disponíveis. Mas o lítio foi proposto como um tratamento potencial. Assim, avaliaou-se a associação entre o uso de lítio e a incidência de demência e seus subtipos.
Foi realizado um estudo de coorte retrospectivo comparando pacientes tratados entre 1º de janeiro de 2005 e 31 de dezembro de 2019, usando dados de registros clínicos eletrônicos de serviços de saúde mental de atenção secundária do Cambridgeshire and Peterborough NHS Foundation Trust (CPFT), do Reino Unido (captação da população da área aproximadamente 0,86 milhões).
Os pacientes elegíveis foram aqueles com idade igual ou superior a 50 anos no início do estudo e que tiveram pelo menos 1 ano de acompanhamento, excluindo pacientes com diagnóstico de comprometimento cognitivo leve (CCL) ou demência antes ou menos de 1 ano após a data de início.
A intervenção foi o uso de lítio. Os principais desfechos foram demência e seus subtipos, diagnosticados e classificados de acordo com a Classificação Internacional de Doenças – 10ª Revisão (CID-10).
Nesta coorte, 29.618 pacientes (dos quais 548 foram expostos ao lítio) foram incluídos. A média de idade foi de 73,9 anos. Um total de 40,2% eram do sexo masculino, 33,3% eram casados ou em união estável e 71,0% eram de etnia branca.
Os pacientes expostos ao lítio eram mais propensos a serem casados, coabitantes ou em união estável, serem fumantes/ex-fumantes, terem usado antipsicóticos e terem depressão comórbida, mania/transtorno afetivo bipolar (TABP), hipertensão, doença vascular central, diabetes mellitus ou hiperlipidemias.
Nenhuma diferença significativa entre os 2 grupos foi observada para outras características, incluindo idade, sexo e transtornos relacionados ao álcool.
Na coorte exposta, 53 (9,7%) pacientes foram diagnosticados com demência, incluindo 36 (6,8%) com doença de Alzheimer (DA) e 13 (2,6%) com demência vascular (DV). Na coortenão exposta, os números correspondentes foram os seguintes: demência 3.244 (11,2%), DA 2.276 (8,1%) e DV 698 (2,6%).
Após o controle de fatores sociodemográficos, tabagismo, outros medicamentos, outras comorbidades mentais e comorbidades físicas, o uso de lítio foi associado a um menor risco de demência (razão de risco [HR] 0,56, intervalo de confiança [IC] de 95% 0,40 a 0,78), incluindo DA (HR 0,55, IC 95% 0,37 a 0,82) e DV (HR 0,36, IC 95% 0,19 a 0,69).
O lítio pareceu protetor em usuários de lítio de curto prazo (≤1 ano) e de longo prazo (>5 anos de exposição); a falta de diferença para durações intermediárias foi provavelmente devido à falta de potência, mas havia alguma evidência de benefício adicional com durações de exposição mais longas.
A principal limitação foi o manuseio do TABP, o motivo mais comum para prescrição de lítio, mas também um fator de risco para demência. Esse potencial confundidor provavelmente causaria um aumento da demência no grupo exposto, enquanto encontrou-se o oposto, e a análise de sensibilidade confirmou os resultados primários. No entanto, a natureza específica do grupo de pacientes expostos ao lítio significa que é necessário cautela ao estender esses achados à população em geral.
Outra limitação é que o tamanho da amostra de pacientes em uso de lítio foi pequeno, refletido nos amplos ICs para resultados relacionados a algumas durações de exposição ao lítio, embora novamente as análises de sensibilidade tenham permanecido consistentes com os achados primários.
Observou-se, assim, uma associação entre o uso de lítio e a diminuição do risco de desenvolver demência. Isso dá mais suporte à ideia de que o lítio pode ser um tratamento modificador da doença para a demência e que este é um tratamento promissor para levar adiante em ensaios clínicos randomizados maiores para essa indicação.
Fontes:
PLoS Medicine, publicação em 17 de março de 2022.
MedPage Today, notícia publicada em 17 de março de 2022.
ALZHEIMER DEMÊNCIA LÍTIO MEDICINA INTEGRATIVA OTORRINOINTEGRATIVA